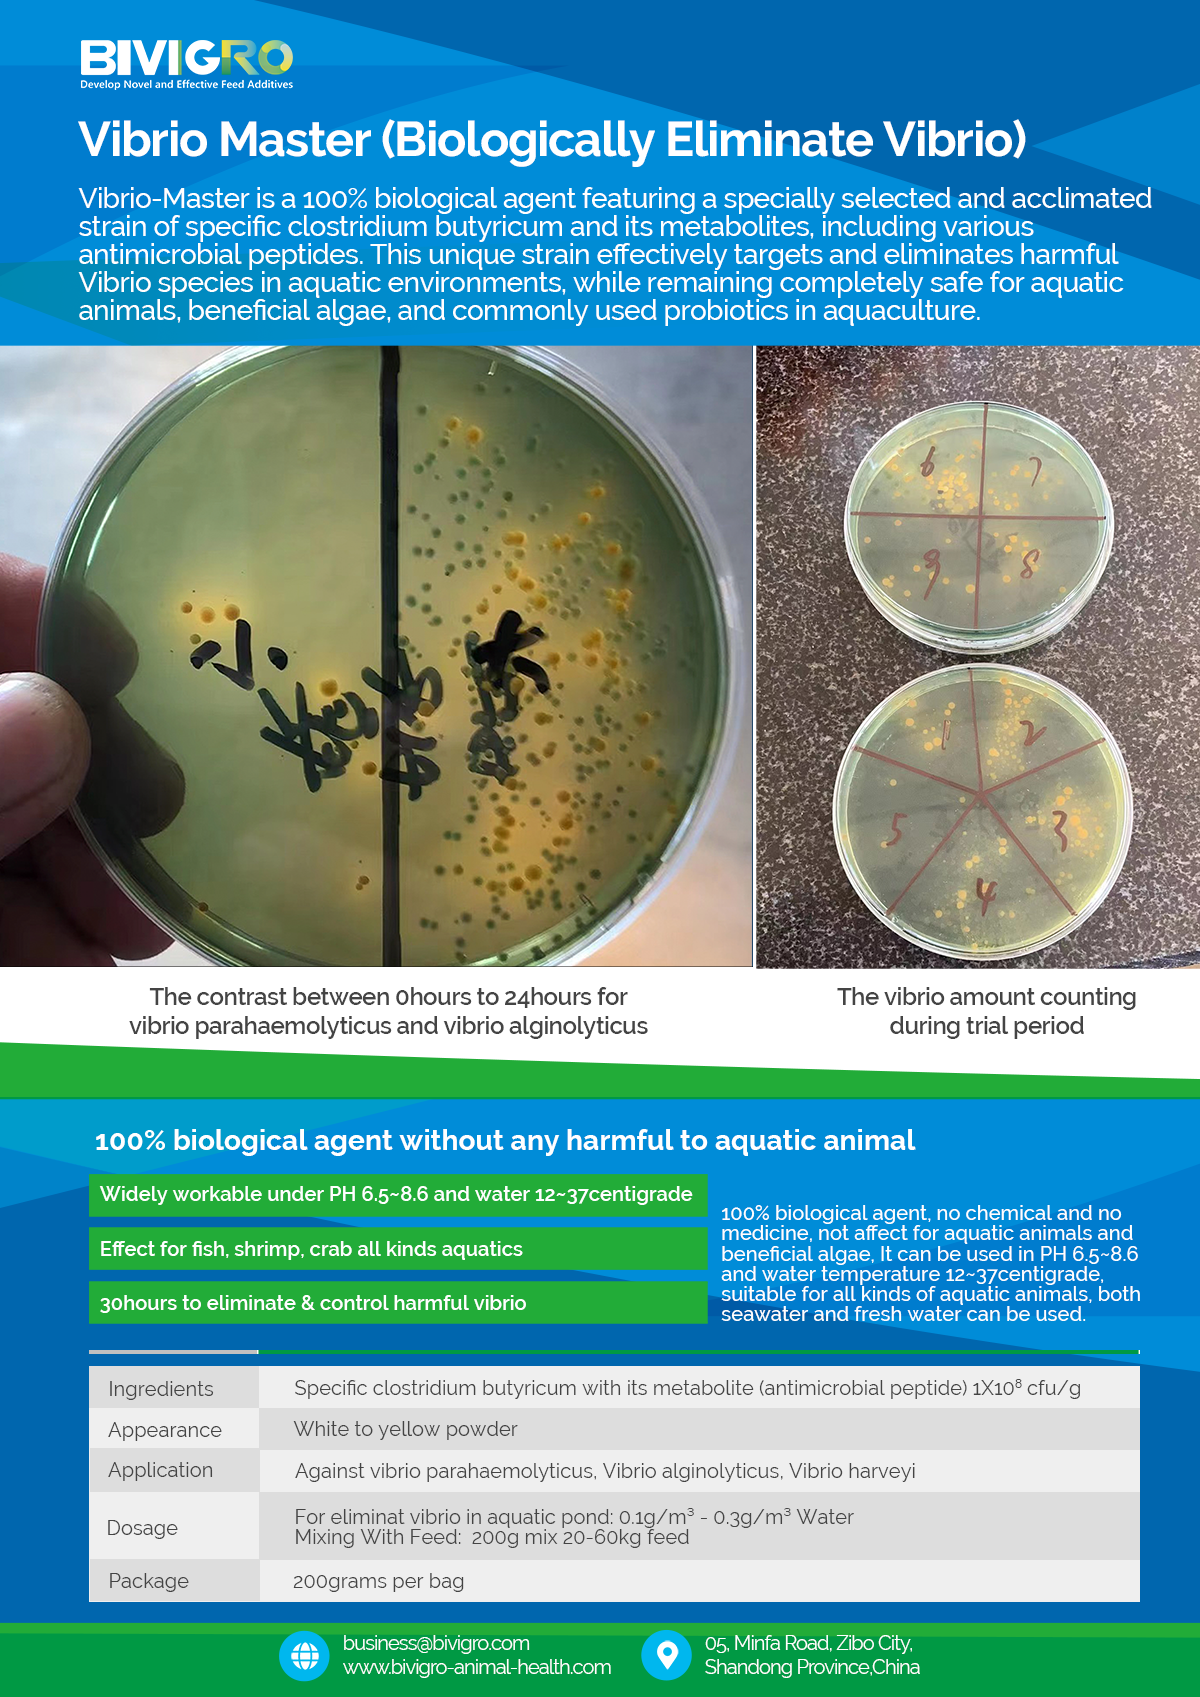

-
Company
-
Feed Mill Purpose
-
Animal Health Purpose
-
Events
-
Contact
-
Follow Us
Navigation
-
PoultryHerb ExtractMulti-Action Growth PromotorNano-Size Herb Extract OilWater-Soluble Herb ExtractYeast & Toxin BinderFunctional Nutrition SupplementDisinfectant
-
AquacultureHerb ExtractMulti-Action Growth PromotorHerb ExtractProbiotic & EnzymeFunctional Nutrition SupplementMulti-VitaminMulti-MineralDisinfectant
-
RuminantHerb ExtractMulti-Action Growth PromotorYeast & Toxin BinderYeastToxin BinderFunctional Nutrition Supplement
Vibrio Master is a new generation biological agent designed to specifically combat harmful Vibrio bacteria in aquaculture. Its core efficacy comes from the specialized antimicrobial peptides produced by our selected strain of Clostridium butyricum. These natural compounds directly target and neutralize Vibrio, providing precise and effective control both in your pond water and within your shrimp or fish.
How It Works: Precision Action
Vibrio Master works through targeted biological mechanisms:
(1) Direct Antimicrobial Action: The specific antimicrobial peptides in our formula actively disrupt and eliminate Vibrio bacteria upon contact.
(2) Environmental & Internal Protection: Works effectively in the water column to reduce Vibrio load and continues to provide protection inside the aquatic digestive system.
(3) Creates a Hostile Environment: Helps establish conditions that are unfavorable for Vibrio survival and proliferation.
Product Features:
(1) Strain-Specific Formula: Utilizes a carefully selected clostridium butyricum strain optimized for maximum antimicrobial peptide production.
(2) Dual-Action Protection: Effective both in water and inside aquatic animals for comprehensive coverage.
(3) Natural & Safe: A biological alternative to chemical treatments, safe for animals and the pond ecosystem.
(4) No Resistance Development: Works through natural antimicrobial mechanisms, minimizing the risk of resistance development.
(5) Easy Application: Suitable for direct water application or feed mixing for convenient integration into your farming routine.
Key Benefits for Your Aquaculture Operation:
(1) Effective Vibrio Reduction: Significantly lowers Vibrio concentrations in pond water and within aquatic animals.
(2) Supports Animal Health: Helps prevent Vibrio-related diseases and supports overall gut health.
(3) Improves Survival Rates: Contributes to better survival, especially during vulnerable growth stages.
(4) Enhances Growth Performance: Healthier animals show improved feed utilization and growth rates.
(5) Sustainable Solution: Supports environmentally responsible farming practices while maintaining effectiveness.
Move beyond conventional approaches with our precision-formulated solution. Vibrio Master delivers effective, natural protection against one of aquaculture's most challenging pathogens.
Related Produtcs
- Aqua Gold Nutrition Pellet
Aqua Gold is a high-performance, multi-nutrient supplement specifically engineered for shrimp farming Formulated as
- Aqua-Liver Star
Aqua Liver Star is a specialized, multi-action health supplement designed to protect and support the core of shri
- Bio-Aminox Liquid Organic Minerals
Bio-Aminox is a premium liquid supplement designed to deliver high-bioavailability nutrition directly to your shrimp
- Cleantec Tablet
Cleantec Tablet is an innovative disinfectant solution designed specifically for shrimp ponds Formulated as potassi
